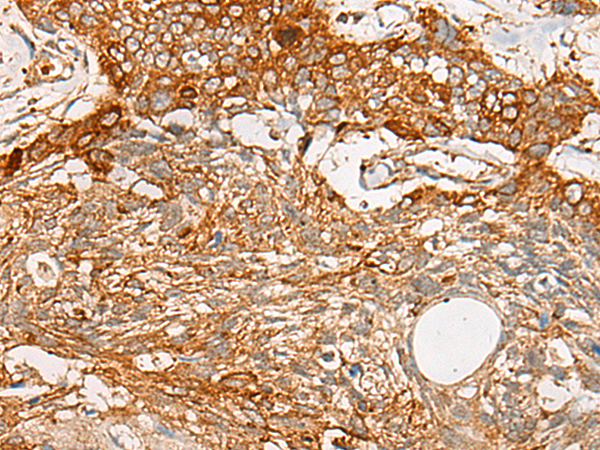

|
ackground: |
SPATA19(spermatogenesis associated 19), also known as spergen1 (spermatogenic cell-specific gene 1 protein), CT132 or SPAS1, is a 167 amino acid mitochondrial outer membrane protein suggested to function in spermiogenesis. Expressed specifically in testis, SPATA19 is encoded by a gene that maps to human chromosome 11, which comprises approximately 4% of human genomic DNA and is considered a gene and disease association dense chromosome. The chromosome 11 encoded Atm gene is important for regulation of cell cycle arrest and apoptosis following double strand DNA breaks. Atm mutation leads to the disorder known as ataxiatelangiectasia. The blood disorders Sickle cell anemia and thalassemia are caused by HBB gene mutations, while Wilms’ tumors, WAGR syndrome and Denys-Drash syndrome are associated with mutations of the WT1 gene. Jervell and Lange-Nielsen syndrome, Jacobsen syndrome, Niemann-Pick disease, hereditary angioedema and Smith-Lemli-Opitz syndrome are also associated with defects in chromosome 11-encoded genes. |
|
Applications: |
ELISA, IHC |
|
Name of antibody: |
SPATA19 |
|
Immunogen: |
Fusion protein of human SPATA19 |
|
Full name: |
spermatogenesis associated 19 |
|
Synonyms: |
CT132; SPAS1; spergen1 |
|
SwissProt: |
Q7Z5L4 |
|
ELISA Recommended dilution: |
5000-10000 |
|
IHC positive control: |
Human esophagus cancer and Human ovarian cancer |
|
IHC Recommend dilution: |
25-100 |

購物車
購物車 幫助
幫助
 021-54845833/15800441009
021-54845833/15800441009
